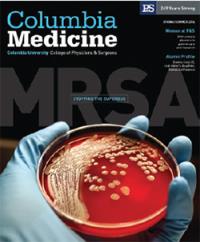
Cover of Columbia Medicine Spring/Summer 2016 issue.

Letters
Hattie Alexander and Superbugs
I was very pleased to read about two of my favorite topics in the Spring/Summer 2016 issue of Columbia Medicine: “Stopping the Superbug” and the article, “First in Class: Hattie E. Alexander, MD 1901-1968.” Personally, I am involved in MRSA research and other “superbugs” and appreciate the research approach on Staphylococcus aureus at Columbia.
I also collect antique microscopes and study the history of microbiology. About five years ago, I purchased the original microscope, box, and accessories of Dr. Hattie Alexander. Since then, I have learned much about her life and research. The connection of my two interests is that Hattie Alexander was one of the earliest researchers to study antibiotic resistance. In fact in the same year (1946) that Alexander Fleming pointed out the danger to overusing penicillin (i.e., drug resistance), Hattie Alexander found resistance to streptomycin in Haemophilus influenzae. This discovery made her the first to see drug resistance in bacteria other than S. aureus. She would continue to study (with others) antibiotic resistance in Haemophilus influenzae for most of her career and published at least on it until 1966, the time of her retirement. You might say she was one of the original “superbug” researchers. I am writing to see if anyone reading this publication knew her personally and could tell me more about her life than published papers tell. If so, please contact me at algillen@liberty.edu.
Dr. Alan Gillen
Professor of Microbiology, Liberty University
Women at P&S
I thoroughly enjoyed the article on women long denied a role at P&S (Spring/Summer 2016 issue). I was a P&S student during the years 1949 to 1953. I was greatly influenced by several of my mentors at Columbia. In my career I initiated and became department chairman and professor of ophthalmology at Yale University School of Medicine. I am now enjoying professor emeritus status. My research and clinical adventures were productive and happy. I mentored many women (and men) in my residency program and through my own research and research fellowships, including many who became American and overseas professors and chairs.
I was so happy the article mentioned Virginia Apgar and Virginia Frantz, teachers and leaders at the time. Additionally there was Helen Ranney, many years an associate editor of the New England Journal of Medicine and a great hematologist. She along with the two previously mentioned professors comprised a good bit of my education when I was a student at Columbia.
Other women worth noting include Balbina A. Johnson, who collaborated with Frank Meleney on the joint discovery of bacitracin. As a student, I spent a summer in their laboratory. I also remember Hattie Alexander and Dorothy Andersen. I cannot understand why more recognition has not been given to these pioneers. I have been lecturing everyone I meet about these heroes for several years.
I am gratified to have read this article.
Marvin Sears’53
Via email
Editor’s Note: Several readers notified us about mismatched names on mailing labels on the Spring/Summer 2016 issue. The middle name/initial field was shifted in the spreadsheet used to prepare mailing labels, so several recipients received magazines with mailing labels just a bit off their real names. Columbia Medicine gets new lists from multiple databases before each issue, so this mix-up should not happen again.